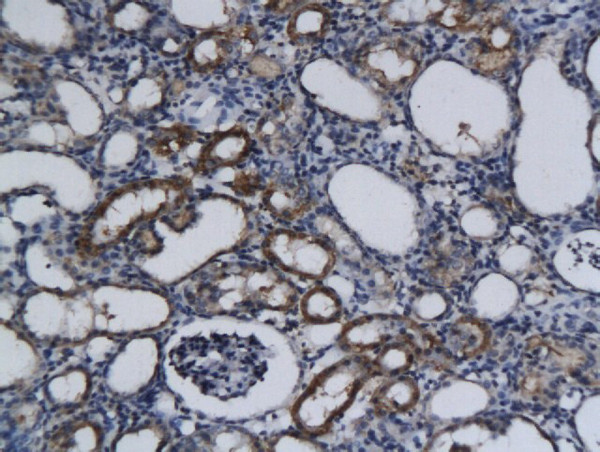
Phospho-c-Kit (Tyr721) Antibody in Immunohistochemistry (Paraffin) (IHC (P))

Search
Bioss
Phospho-c-Kit (Tyr721) Polyclonal Antibody
{{$productOrderCtrl.translations['antibody.pdp.commerceCard.promotion.promotions']}}
{{$productOrderCtrl.translations['antibody.pdp.commerceCard.promotion.viewpromo']}}
{{$productOrderCtrl.translations['antibody.pdp.commerceCard.promotion.promocode']}}: {{promo.promoCode}} {{promo.promoTitle}} {{promo.promoDescription}}. {{$productOrderCtrl.translations['antibody.pdp.commerceCard.promotion.learnmore']}}
产品信息
BS-3242R
种属反应
宿主/亚型
分类
类型
抗原
偶联物
形式
浓度
规格
纯化类型
保存液
内含物
保存条件
运输条件
靶标信息
KIT (c-KIT) is a proto-oncogene and a type 3 transmembrane receptor for MGF (mast cell growth factor, also known as stem cell factor). KIT was first identified as the cellular homolog of the feline sarcoma viral oncogene v-kit. KIT together with its ligand regulates growth and activation of a variety of hemopoietic and non-hemopoietic cells. Mutations in KIT are associated with gastrointestinal stromal tumors, mast cell disease, acute myelogenous leukemia, and piebaldism. Recently, deregulation of the KIT receptor TK by the prevalent activation loop mutation D816V has served as a focal point in therapeutic strategies aimed at curbing neoplastic mast cell growth. c-Kit is expressed in hematopoietic stem cells, germ cells, mast cells and gastrointestinal tract cajal cells. Upon binding of its ligand stem cell factor (SCF), c-kit dimerizes, resulting in receptor activation and autophosphorylation of various tyrosine residues including tyrosine 703 located on the cytoplasmic domain of the receptor. This modification allows docking of Grb2 and activation of the Ras/ERK signaling pathway. SCF/c-kit can activate multiple downstream signaling pathways including PI3K, PLC-gamma and JAK/STAT. c-kit receptor activation is essential for hematopoiesis, stem cell maintenance and gametogenesis.
仅用于科研。不用于诊断过程。未经明确授权不得转售。
篇参考文献 (0)
生物信息学
蛋白别名: belly-spot; c-Kit; c-KIT gene1; c-kit proto-oncogene protein; c-Kit protooncogene; c-kit receptor tyrosine kinase; CD117; ckit; dominant spotting; Dominant white spotting; Mast/stem cell growth factor receptor Kit; p145 c-kit; PBT; Piebald trait protein; protein kinase; Proto-oncogene c-Kit; proto-oncogene tyrosine-protein kinase Kit; receptor tyrosine kinase c-kit; receptor tyrosine kinase type III; SCFR; spotted sterile male; Steel Factor Receptor; Tyrosine-protein kinase Kit; unnamed protein product; v-kit Hardy-Zuckerman 4 feline sarcoma viral oncogene homolog; v-kit Hardy-Zuckerman 4 feline sarcoma viral oncogene-like protein
基因别名: Bs; C-Kit; CD117; Fdc; Gsfsco1; Gsfsco5; Gsfsow3; KIT; MASTC; PBT; SCFR; SCO1; SCO5; Sl; SOW3; Ssm; Tr-kit; W
UniProt ID: (Dog) O97799, (Human) P10721, (Mouse) P05532
Entrez Gene ID: (Dog) 403811, (Human) 3815, (Rat) 64030, (Mouse) 16590